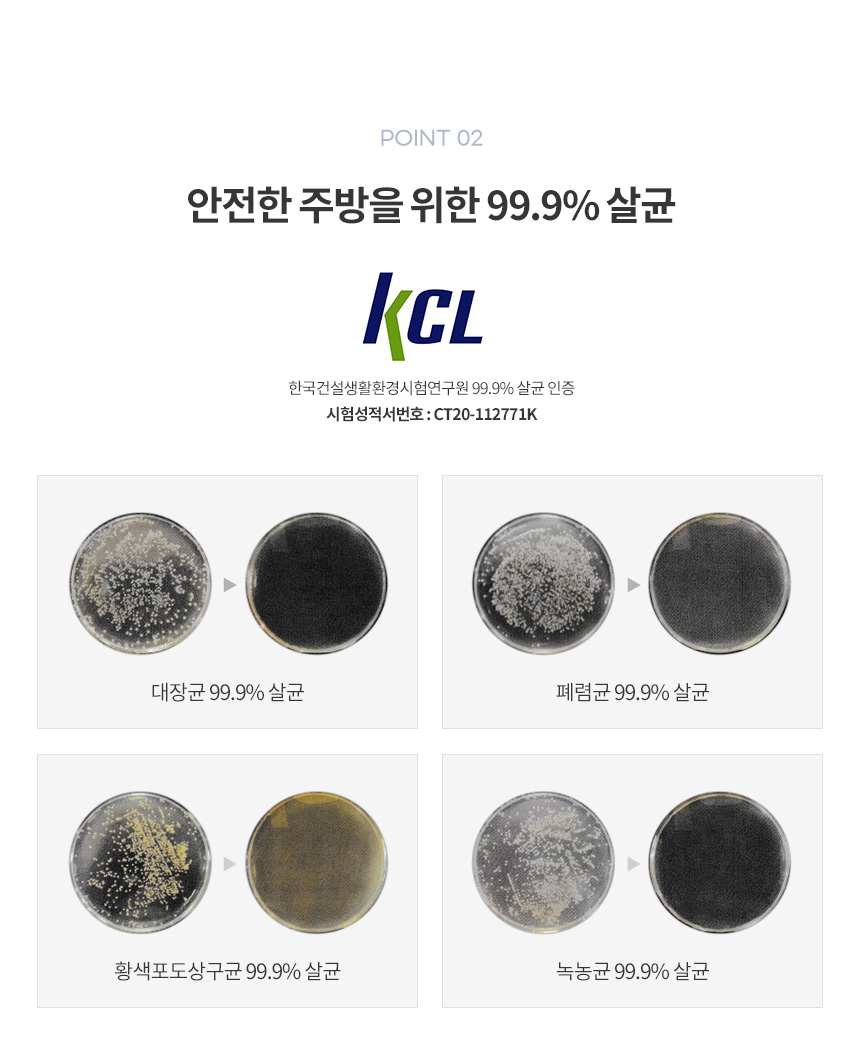

'포트폴리오 > 상세페이지' 카테고리의 다른 글
| 신일 써큘레이터형 벽걸이 리모컨 선풍기 상세페이지 (0) | 2021.03.23 |
|---|---|
| 신일 미니인덕션 상세페이지 (0) | 2021.03.15 |
| 프로폼롤러 미니폼롤러 상세페이지 (0) | 2021.02.19 |
| 이스타 무선청소기 상세페이지 (0) | 2021.02.19 |
| 유선 진공청소기 상세페이지 (0) | 2021.01.21 |

| 신일 써큘레이터형 벽걸이 리모컨 선풍기 상세페이지 (0) | 2021.03.23 |
|---|---|
| 신일 미니인덕션 상세페이지 (0) | 2021.03.15 |
| 프로폼롤러 미니폼롤러 상세페이지 (0) | 2021.02.19 |
| 이스타 무선청소기 상세페이지 (0) | 2021.02.19 |
| 유선 진공청소기 상세페이지 (0) | 2021.01.21 |